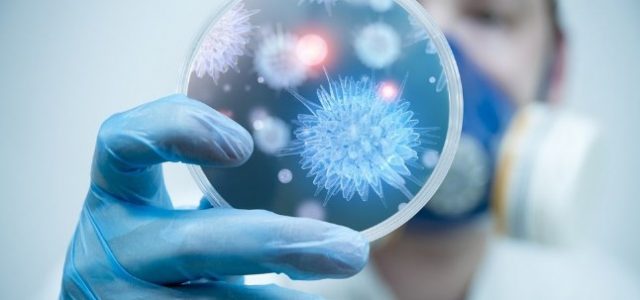

Koronavirus tehlikesinin ne boyutta ve nasıl bir anda tüm ülkeyi etkileyebileceğini Kore’de yaşayan bir kardeşiniz olarak anlatayım.
- Kore virüs olayları Çin’de patlak verdikten sonra ateş ölçerle Çin’den yolcu kabul etti. Daha sonra bir kişi bu testi Geçtikten 20 gün sonra hastaneye giderek tedavi altına alındı. Ve kendisinde Corona teşhis edildi.
- Bu ve kuluçka döneminde çini ziyaret edip gelenlerin çoğunda kuluçka dönemi olduğu anlaşılınca Çine uçuşlar durduruldu. Sıkı bir takip başladı bu kişilere ulaşılarak Tek tek test edildi ve bu kişilerin iletişime geçtiği bütün kişiler,taksici, bir otelde asansörde karşılaştıkları herhangi bir kişi dahil kontroller yapıldı. İlk 20 gün sadece 30 kişide virüs görüldü çünkü gerçek anlamda tedbir almıştı hükümet.
- Ancak hava alanından henüz kimin neden olduğu bilinmemekle beraber ateş ölçer testinden geçen bir kişi ülkenin güneyinde bir kadına virüs bulaştırmis. Bu kadın yaklaşık bir ay hristiyan bir tarikatın kilise ayinleride katıldı.
- Aradan 20 gün geçtikten sonra 31. Hasta olarak Bu kadına teşhis koyuldu ve ismine ” süper yayıcı ” denilmeye başlandı. Bu kadının tarikat üyeleri kontrol edilmeye başlandı 2 gün içinde 560 kişi daha virüs nedeniyle tedaviye alındı . Şuan Hergün 200 yeni virüs vakası bildirmeye başladı hükümet.
- Asıl sorun şimdi şudur ; Süper yayıcı kadın yurt dışında bulunmadı. Kısa zaman önce yurt dışına gidip gelen bir kişiyle de temas etmemiş. Bu durumda kadına , yolda veya alışveriş yaptığı bir mağazada yani kamusal alanda virüs bulaştı.
- Ve bu kadın bunu bilmediği için tarikatının ayinlerine katılmaya devam etti. Şuan sadece bir kişi yaklaşık 2 bin kişiye virüs bulaştırmis gibi görünüyor Birde bu 2 bin kişinin bulaştırdıklarını aramaya başladılar. Durumun nasıl kontrolden çıkmaya başladığını anlamışsınızdır.
- Demem o ki , İran’dan veya virüs görülmüş herhangi bir ülkeden gelecek olan bir kişi kuluçka döneminde tespit edilemeyecektir. Ve bu bir kişi bile olsa , taxiye binecek , otele gidecek , marketten alışveriş yapacak. Ve bu Silsile belkide taxsici marketçi ve Otel görevlisinin istemsiz virüsü yaymasiyla milyonları bulabilir.
- Eğer bu zamana kadar virüs girdiyse kuluçka döneminde olan bir hastayla , artık önümüze bakmalı hükümet eğer girmediğini düşünüyorsak virüslü ülkelerden gelen uçakları geri göndermeye başlamalıyız.
- Durum çok ciddi. Güney Kore’de Hergün durum kötüye gidiyor gibi duruyor. Açıkçası kontrolden çıkabilir… Türkiyem gerekli önlemleri alsın diyerek burada gördüklerimi anlatma ihtiyacı duydum. Teşekkür ederim..

Virüse karşı nasıl korunuruz. Çin yönetiminin ilk günden beri yaptığı tavsiyeler. Bunları bilmeniz faydalı olacaktır:
- 1-Öncelikle bu hastalığın bir ilacı veya aşısı yok. 2-Bu süreçte en önemli şey insanlarla mümkün olduğunca az temas kurmak. Kalabalık ortamlardan uzak durulmalı.
- 3-Hijyene kesinlikle dikkat edin. Sık sık ellerinizi sabunla yıkayın. Özellikle dışarı gidip gelmelerinizden sonra. 4-Grip belirtisi olan insanlardan uzak durun. 5-Dışardayken ellerinizle gözlerinize ve burnunuza kesinlikle dokunmayın.
- 6-Maske kullanmak çok önemli bu süreçte. 7-Bir de hapşıran tıksıran arkadaşlar lütfen bir peçete ile ağzınızı kapatın. 8-Meyve ve sebzelerinizi iyice yıkayın. 9-Bir de bağışıklık sisteminizi güçlü tutmak çok önemli bu süreçte.
Salgınından korunabilme adına en önemli adım olan uygun maske kullanımı…

Pelikan Grubu | Pelikancılar Kimdir?
Menzil Tarikatı; Gavs Kimdir? Nasıl Çalışırlar? Mal Varlıkları Nedir?
Serkan Kurtuluş Kimdir?
Kesinleşmiş Cezanın ne kadarı Cezaevinde yatılır! (‘Cezamın yatarı ne Avgat Bey?’)
Corona Virüsü
Yeşil kod adlı; Mahmut Yıldırım Yaşıyor mu?
Türkiye’deki Cezaevi Tür ve Tipleri hakkında pratik bilgiler!
Kur’an-ı Kerim’de Bilim ile İlgili Ayetler? (‘Kur’an bilime yönlendirir!’)
Erkekler neden mesaj yazmaz? Kızlar neden mesaj atmaz?
Akp’nin Yasadışı silahlı eğitim kampları! (‘İç Savaş Hazırlığı, Görüntüler – İddialar’)
Osmanlıca Küfür
Twin Flame
Atatürk’ün dedesi kimdir? | Soy Ağacı
Dr. Mehmet Öz; Corona Virüsü
Türkiye Yunanistan Askeri Gücü Karşılaştırması
David Rockefeller, Servetinin sınırlarına yolculuk! Ve Türkiye’deki Temsilcileri!
Adolf Hitler’in Propaganda Bakanı Joseph Goebbels’in Sözleri
Şehidimiz Var; Albay Okan Altınay
Rabıta Nedir? Nasıl Yapılır?
Ölün İstiyorum Artık | Nejat İşler
[…] Mutlaka Oku; Corona Virüsü Nasıl Bulaşır? […]